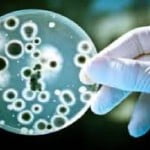
infez

12 ott – Migranti, nomadi e giovani disoccupati sono le categorie per cui il rischio di malattie infettive è aumentato in questi anni a causa della crisi economica. Lo afferma un rapporto del’European Centers for Diseases Control (Ecdc) basato sulla revisione delle principali ricerche recenti sul tema.
12 ott – Migranti, nomadi e giovani disoccupati sono le categorie per cui il rischio di malattie infettive è aumentato in questi anni a causa della crisi economica. Lo afferma un rapporto del’European Centers for Diseases Control (Ecdc) basato sulla revisione delle principali ricerche recenti sul tema.
Secondo il documento sono già molti gli esempi di questo fenomeno, dall’aumento delle infezioni correlate all’uso di droga come l’Hiv al boom di epatiti registrate negli strati più svantaggiati della popolazione. I giovani disoccupati, in aumento in Europa, sono particolarmente a rischio. ”La disoccupazione aumenta lo stress, e questo ha ripercussioni sulla salute – scrivono gli esperti – inoltre perdere il lavoro aumenta la propensione ai comportamenti a rischio, dal consumo di alcol al fumo alle droghe”.
Per quanto riguarda le popolazioni migranti il documento sottolinea che i rischi sono molto maggiori una volta che arrivano in Europa. ”Generalmente i migranti sono più in salute della media della popolazione – scrivono ma una volta arrivati hanno minor accesso ai servizi di prevenzione e cura, e questo li rende più suscettibili”. Gli stessi problemi, indica il rapporto, ci sono per le popolazioni nomadi, che pur vivendo stabilmente all’interno dell’Unione Europea non hanno accesso ai servizi anche a causa di alcune discriminazioni riferite da parte del personale medico e amministrativo.(ANSA).



